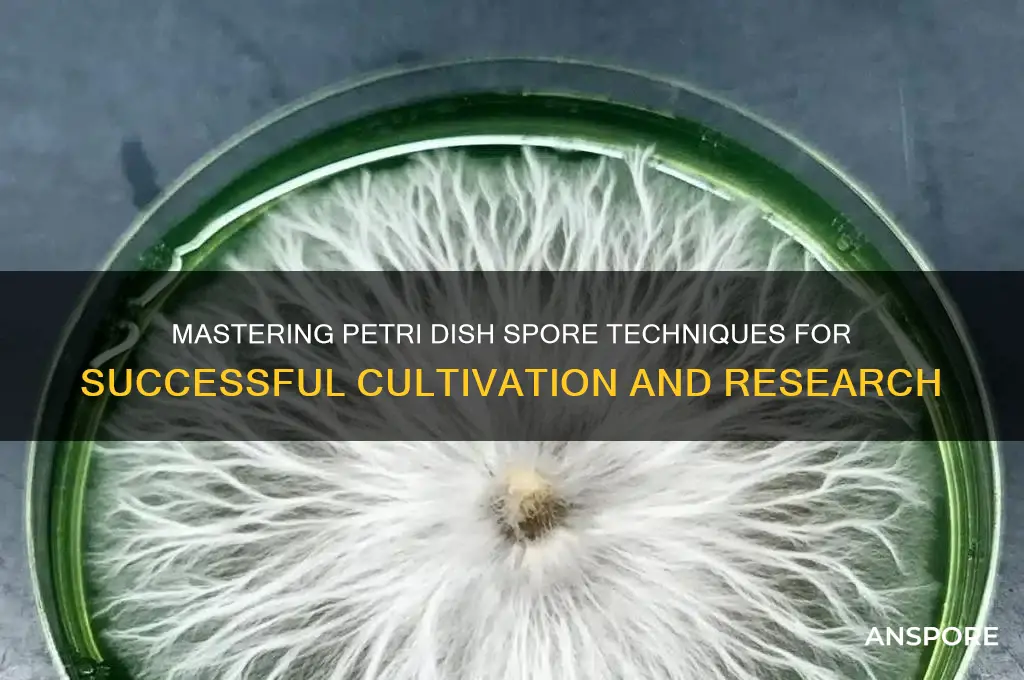
how to use petri dish spores

Using petri dish spores is a fundamental technique in microbiology for cultivating and studying microorganisms. The process begins by sterilizing the petri dish and nutrient agar to create a contamination-free environment. Spores, which are highly resilient dormant forms of certain bacteria, fungi, or other microbes, are then carefully introduced onto the agar surface using sterile techniques, such as a flame-sterilized inoculating loop or a spore suspension. The dish is incubated at an optimal temperature to encourage spore germination and microbial growth. Over time, colonies form, allowing researchers to observe, identify, and analyze the microorganisms. This method is widely used in scientific research, education, and industrial applications, such as antibiotic testing and food safety assessments. Proper handling and aseptic techniques are crucial to ensure accurate and reliable results.
| Characteristics | Values |
|---|---|
| Purpose | Culturing microorganisms (bacteria, fungi, etc.) from spores |
| Sterilization | Petri dishes and tools must be sterilized (autoclave, flaming) to prevent contamination |
| Media Preparation | Use nutrient agar or specific media suitable for the target organism |
| Cooling | Allow molten agar to cool to ~50°C before pouring into petri dishes |
| Agar Depth | Pour ~20-25 ml of agar into each dish for a uniform layer |
| Solidification | Let agar solidify completely (15-30 minutes) in a sterile environment |
| Spore Inoculation | Use a sterile swab, loop, or spore suspension to transfer spores onto the agar surface |
| Streaking Technique | Use the quadrant or "Z" streak method for isolation of single colonies |
| Incubation | Incubate at optimal temperature (e.g., 37°C for bacteria) for 24-48 hours |
| Humidity Control | Maintain proper humidity to prevent agar dehydration (inverted position or humid chamber) |
| Observation | Examine for colony growth, morphology, and characteristics |
| Contamination Check | Inspect for unwanted growth (e.g., mold, yeast) |
| Storage | Store unused spore suspensions at 4°C or -20°C (long-term) |
| Safety | Work in a biosafety cabinet or laminar flow hood; follow aseptic techniques |
| Disposal | Autoclave used dishes and waste before disposal |
What You'll Learn
- Preparing the Petri Dish: Sterilize, cool, and label the dish before use
- Collecting Spores: Use sterile swabs or air sampling for spore collection
- Inoculating the Dish: Gently spread spores evenly across the agar surface
- Incubating Spores: Maintain optimal temperature and humidity for spore growth
- Observing Growth: Monitor daily for colony formation and characteristics

Preparing the Petri Dish: Sterilize, cool, and label the dish before use
Sterilization is the cornerstone of successful petri dish experiments. Even a single contaminant can compromise your results, rendering hours of work useless. Autoclaving, a process using high-pressure steam at 121°C for 15-20 minutes, is the gold standard for sterilizing petri dishes. This method ensures the elimination of bacteria, fungi, and their spores, creating a pristine environment for your desired microorganisms to thrive.
Remember, a properly sterilized dish will appear dry and free of any visible debris or discoloration.
Cooling the petri dish after sterilization is a step often overlooked, yet crucial. Placing a hot dish directly under a laminar flow hood or in a sterile environment can introduce contaminants from the air. Allow the dish to cool to room temperature, approximately 25°C, before handling. This prevents condensation from forming inside the dish, which can dilute your spore suspension and hinder growth. Patience during this stage is key to ensuring the integrity of your experiment.
Labeling your petri dishes with clear, concise information is essential for organization and data tracking. Include the date, spore type, dilution (if applicable), and any relevant experimental conditions. Use a permanent marker designed for writing on plastic surfaces, ensuring the label remains legible throughout the incubation period. A well-labeled dish prevents confusion, allows for easy identification, and facilitates accurate data analysis.
Consider using a color-coding system for different spore types or experimental groups to further enhance organization and minimize errors. By meticulously sterilizing, cooling, and labeling your petri dishes, you establish a solid foundation for successful spore cultivation and accurate experimental results. These seemingly simple steps are the building blocks of reliable scientific inquiry.
Mastering Psilocybin Cultivation: Collecting Cubensis Spores for Successful Growth
You may want to see also

Collecting Spores: Use sterile swabs or air sampling for spore collection
Sterile swabs and air sampling are two primary methods for collecting spores, each suited to different environments and objectives. Sterile swabs are ideal for targeted collection from surfaces, such as soil, plants, or laboratory equipment, where precision is key. Dip the swab in sterile water or a buffer solution to prevent desiccation, then gently rub it over the target area in a consistent pattern (e.g., a zigzag or grid) to dislodge spores. Immediately streak the swab onto a nutrient agar plate in a petri dish, ensuring even distribution for optimal growth. This method is particularly useful for isolating specific spore types in controlled settings.
Air sampling, on the other hand, captures airborne spores using devices like impactors or filters. A common tool is the air sampler, which draws a measured volume of air (e.g., 100 liters) through a petri dish containing agar media. Spores impact the agar surface, where they can germinate and form colonies. This method is essential for monitoring indoor air quality, studying fungal ecology, or detecting pathogens in clinical settings. For accurate results, place the sampler at breathing height (1–1.5 meters) and run it for 2–5 minutes, depending on spore concentration and desired detection sensitivity.
While both methods are effective, they require strict aseptic technique to avoid contamination. Sterilize all tools (swabs, tweezers, etc.) with ethanol or flame before use, and work in a laminar flow hood or near an open flame to minimize airborne contaminants. Label samples with collection date, time, and location for traceability. For air sampling, ensure the agar media is solidified and free of condensation before use, as moisture can interfere with spore viability.
A critical consideration is the choice of agar media. Potato dextrose agar (PDA) is widely used for fungi due to its nutrient richness, while malt extract agar (MEA) is preferred for certain spore types like molds. For bacteria, nutrient agar or selective media (e.g., MacConkey agar) may be appropriate. Incubate plates at species-specific temperatures (e.g., 25°C for fungi, 37°C for bacteria) for 24–72 hours, monitoring for colony growth, morphology, and color, which aid in identification.
In practice, combining both methods can provide a comprehensive spore profile. For instance, use air sampling to assess ambient spore levels and sterile swabs to pinpoint contamination sources. Document environmental conditions (humidity, temperature) during collection, as these influence spore dispersal and viability. With careful technique and appropriate tools, spore collection becomes a powerful means of studying microbial life, diagnosing infections, or ensuring environmental safety.
Seeds vs. Spores: Unveiling the Differences in Plant Reproduction
You may want to see also

Inoculating the Dish: Gently spread spores evenly across the agar surface
The delicate dance of inoculation begins with a light touch. Imagine a painter's brushstroke, but instead of pigment, you're spreading life. A sterile loop, cooled to room temperature, becomes your instrument, gently whisking spores from their source and onto the agar's waiting canvas. This initial contact is crucial; too heavy-handed, and you risk clumping, depriving spores of the oxygen and nutrients they need to thrive. Too timid, and you'll leave barren patches, hindering colony growth.
Aim for a thin, even layer, like a fine dusting of snow on a winter morning.
This seemingly simple step holds profound implications. The uniformity of spore distribution directly impacts the success of your experiment. Uneven spreading can lead to skewed results, with some colonies receiving an unfair advantage in resources. Imagine a race where some runners start closer to the finish line – hardly a fair competition. By ensuring even distribution, you create a level playing field, allowing each spore an equal opportunity to germinate and grow, providing a more accurate representation of their true potential.
Think of it as democratic microbiology, where every spore gets a vote.
Mastering this technique requires practice and a keen eye. Hold the loop at a shallow angle, allowing the spores to gracefully glide across the agar's surface. Avoid pressing down, as this can damage the agar and trap spores beneath the surface, hindering their access to oxygen. Remember, you're not stirring a pot, but rather, delicately arranging a microscopic garden. With patience and precision, you'll achieve a beautifully uniform lawn of colonies, a testament to your skill and the vibrant world of microorganisms.
Do Peanuts Have Spores? Unraveling the Truth About Peanut Reproduction
You may want to see also

Incubating Spores: Maintain optimal temperature and humidity for spore growth
Spores, those resilient microscopic survivalists, require precise environmental conditions to awaken from dormancy and flourish. Incubation is their cradle, and temperature and humidity are the lullabies that coax them into growth. Deviations from optimal ranges can stall germination or foster contaminants, rendering your petri dish a microbial wasteland.
The Goldilocks Zone: Temperature Precision
Most fungal spores thrive between 22°C and 28°C (72°F–82°F), though bacterial spores often prefer slightly higher temperatures, around 30°C–37°C (86°F–98.6°F). Use an incubator with a digital thermostat to maintain consistency within ±1°C. Fluctuations can disrupt metabolic processes, delaying growth or causing uneven colony development. For hobbyists without an incubator, a proofing oven set to low heat or a DIY setup with a heating pad and thermometer can suffice, but monitor vigilously.
Humidity: The Silent Orchestrator
Spores absorb moisture to initiate metabolic activity, making humidity as critical as temperature. Aim for 80–90% relative humidity inside the incubator. Achieve this by placing a shallow tray of sterilized water or a damp paper towel beneath the petri dishes. For bacterial cultures, a saturated salt solution (e.g., potassium chloride) can stabilize humidity at 84%. Avoid oversaturation, as excess moisture promotes mold or condensation, which can drown delicate colonies.
Practical Tips for Success
Seal petri dishes with parafilm or surgical tape to retain moisture while allowing gas exchange. Rotate dishes daily to counteract uneven heating or cooling within the incubator. For long-term projects, log temperature and humidity readings twice daily to identify trends. If using ambient air incubation, choose a location away from drafts, direct sunlight, or temperature-fluctuating appliances like refrigerators.
Troubleshooting Common Pitfalls
Slow or absent growth? Verify your incubator’s calibration with a secondary thermometer and hygrometer. Contamination? Sterilize all equipment with 70% ethanol and work in a clean, draft-free area. Uneven colonies? Ensure spores are evenly distributed by gently swirling the agar before it solidifies or using a sterile spreader.
Mastering incubation transforms spore cultivation from guesswork into science. With precision in temperature and humidity, you’ll unlock the dormant potential within each spore, nurturing vibrant colonies that reveal the hidden beauty of microbial life.
Showcase Your Spore Creations: A Guide to Uploading to Sporepedia
You may want to see also

Observing Growth: Monitor daily for colony formation and characteristics
The first 24 hours after inoculation are critical for spore germination. During this phase, spores absorb water, swell, and initiate metabolic activity. While visible changes are minimal, this period sets the stage for colony development. Use a magnifying glass or low-power microscope to inspect for subtle signs of hydration or cracking in the spore coat, indicating successful activation. Avoid disturbing the dish during this delicate window, as vibrations can disrupt germination.
Daily observation becomes crucial after the initial 48 hours, when colonies begin to emerge. Document the appearance of each colony, noting size, shape, color, texture, and margin characteristics. For example, bacterial colonies often appear as circular, raised, or smooth structures, while fungal colonies may display filamentous growth or distinct pigmentation. Compare observations across days to track growth rate and morphological changes. Maintain a consistent lighting angle and background for accurate visual comparisons, and use a ruler or grid overlay for precise size measurements.
Environmental factors significantly influence colony characteristics, making controlled conditions essential for reliable observations. Fluctuations in temperature, humidity, or light exposure can alter growth patterns or introduce contaminants. For instance, temperatures above 37°C may inhibit mesophilic bacteria, while mold spores thrive in high-humidity environments. Record ambient conditions daily alongside growth observations to identify correlations. If using an incubator, ensure temperature stability within ±0.5°C and avoid frequent lid opening, as this introduces airborne contaminants and disrupts internal conditions.
Advanced monitoring techniques enhance data accuracy and depth. Incorporate photography using a fixed camera setup to create a time-lapse record of colony development. For quantitative analysis, use software tools to measure colony diameter, density, or color intensity from images. In educational settings, engage participants by assigning specific colonies for tracking, fostering individual responsibility and detailed observation skills. Always label dishes with inoculation date, spore type, and environmental parameters to prevent confusion during long-term studies.
Conclude daily monitoring when colonies reach the dish’s edge or merge, typically within 5–7 days for bacteria and 7–14 days for fungi. At this stage, assess final colony morphology and density to draw conclusions about spore viability or environmental impact. Preserve representative samples by sealing the dish with parafilm or transferring colonies to a sterile slide for microscopy. Discard remaining cultures according to biosafety protocols, avoiding environmental contamination. Consistent, meticulous observation transforms raw growth data into actionable insights, whether for scientific research, educational demonstrations, or quality control applications.
Mastering the Art of Growing Giant Creeper Spores: A Step-by-Step Guide
You may want to see also
Frequently asked questions
Petri dish spores are used to cultivate and study microorganisms, such as bacteria, fungi, or algae, in a controlled environment for research, education, or diagnostic purposes.
Sterilize the petri dish, pour a nutrient agar medium into it, allow it to solidify, and ensure the dish remains sterile until ready for spore inoculation.
Use a sterile inoculation loop or swab to transfer spores onto the agar surface, streak or spread them evenly, and incubate the dish at the appropriate temperature for growth.
Growth time varies by organism, but typically ranges from 24 to 72 hours for bacteria and fungi, depending on incubation conditions and spore type.

